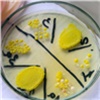
Ученые из Красноярска рассказали, чем пахнут опасные бактерии

Лента новостей / В Красноярском крае / стр. 5220
- 12:53
-
 Красноярский край получил федеральную награду за развитие дорожной инфраструктуры
12 Награждение состоялось на форуме «Транспортная неделя».
Красноярский край получил федеральную награду за развитие дорожной инфраструктуры
12 Награждение состоялось на форуме «Транспортная неделя».
- 11:38
-
 В Дудинке женщина отдала лжеследователям больше 2 млн рублей
13 В Дудинке мошенники под видом следователей похитили у женщины 2,2 млн рублей.
В Дудинке женщина отдала лжеследователям больше 2 млн рублей
13 В Дудинке мошенники под видом следователей похитили у женщины 2,2 млн рублей.
- 10:40
-
 В Красноярске в ночном ДТП с двумя иномарками погиб человек (видео)
32 В Центральном районе Красноярска ночью произошло смертельное ДТП.
В Красноярске в ночном ДТП с двумя иномарками погиб человек (видео)
32 В Центральном районе Красноярска ночью произошло смертельное ДТП.
- 9:00
-
 Кукольный «Котенок по имени Гав», примирение Моцарта с Сальери и народный фестиваль: чем заняться на выходных в Красноярске
2 Культурный гид по Красноярску на новый уикенд.
Кукольный «Котенок по имени Гав», примирение Моцарта с Сальери и народный фестиваль: чем заняться на выходных в Красноярске
2 Культурный гид по Красноярску на новый уикенд.
- 19:37
-
 В Красноярске вице-спикер Государственной Думы Анна Кузнецова посетила соцучреждения
5 В Красноярск на демографический форум приехала вице-спикер Государственной Думы Анна Кузнецова. Вместе с председателем Законодательного Собрания края Алексеем Додатко она посетила два важных для жителей края социальных учреждения.
В Красноярске вице-спикер Государственной Думы Анна Кузнецова посетила соцучреждения
5 В Красноярск на демографический форум приехала вице-спикер Государственной Думы Анна Кузнецова. Вместе с председателем Законодательного Собрания края Алексеем Додатко она посетила два важных для жителей края социальных учреждения.
- 18:47
-
 Почти 2 миллиарда рублей на развитие культуры в Норильске направят в 2026 году
На подпрограмму «Культурное наследие» направят 492,7 млн руб. На подпрограмму «Искусство и народное творчество» выделят 431,3 млн руб.
Почти 2 миллиарда рублей на развитие культуры в Норильске направят в 2026 году
На подпрограмму «Культурное наследие» направят 492,7 млн руб. На подпрограмму «Искусство и народное творчество» выделят 431,3 млн руб.
- 18:20
-
 Три спектакля красноярских театров номинированы на «Золотую маску»
Красноярские театры получили сразу три номинации на национальную премию «Золотая маска».
Три спектакля красноярских театров номинированы на «Золотую маску»
Красноярские театры получили сразу три номинации на национальную премию «Золотая маска».
- 17:50
-
 Глава правительства края подтвердил готовность стать мэром Красноярска
20 Первый заместитель губернатора — председатель правительства Красноярского края Сергей Верещагин выразил готовность стать мэром краевой столицы.
Глава правительства края подтвердил готовность стать мэром Красноярска
20 Первый заместитель губернатора — председатель правительства Красноярского края Сергей Верещагин выразил готовность стать мэром краевой столицы.
- 17:20
-
 В Красноярске устанавливают новые контейнеры для сбора ТКО
11 В Красноярске продолжаются работы по обустройству новых муниципальных площадок для сбора твердых коммунальных отходов.
В Красноярске устанавливают новые контейнеры для сбора ТКО
11 В Красноярске продолжаются работы по обустройству новых муниципальных площадок для сбора твердых коммунальных отходов.
- 17:20
-
 Эксперты Авито рассказали в Красноярске, как найти творческую работу в IT
6 В Красноярск приехала команда ведущих экспертов Авито. В открытом диалоге со студентами они рассказали о творческих IT-профессиях.
Эксперты Авито рассказали в Красноярске, как найти творческую работу в IT
6 В Красноярск приехала команда ведущих экспертов Авито. В открытом диалоге со студентами они рассказали о творческих IT-профессиях.
- 16:50
-
 В Красноярск прилетела зампред Госдумы РФ Анна Кузнецова
38 В Красноярск для участия в демографическом форуме с рабочим визитом прилетела заместитель председателя Государственной Думы РФ Анна Кузнецова.
В Красноярск прилетела зампред Госдумы РФ Анна Кузнецова
38 В Красноярск для участия в демографическом форуме с рабочим визитом прилетела заместитель председателя Государственной Думы РФ Анна Кузнецова.
- 16:20
-
 Красноярцы настояли на изменении проекта научного центра в Академе для сохранения леса
20 Проект «Долина Менделеева» в красноярском Академгородке отправлен на доработку.
Красноярцы настояли на изменении проекта научного центра в Академе для сохранения леса
20 Проект «Долина Менделеева» в красноярском Академгородке отправлен на доработку.
- 16:04
-
 МТС проложила цифровую дорогу к единственному в мире музею Краслага
2 Поселок Тугач стал одним из десяти населенных пунктов Ирбейско-Саянского округа, где специалисты МТС установили телеком-оборудование в 2025 году.
МТС проложила цифровую дорогу к единственному в мире музею Краслага
2 Поселок Тугач стал одним из десяти населенных пунктов Ирбейско-Саянского округа, где специалисты МТС установили телеком-оборудование в 2025 году.
- 16:00
-
 В Красноярске ищут подрядчика для строительства школы в Октябрьском районе
8 В Красноярске объявили торги на поиск подрядчика для строительства новой школы, стартовая цена контракта — 2,6 млрд рублей.
В Красноярске ищут подрядчика для строительства школы в Октябрьском районе
8 В Красноярске объявили торги на поиск подрядчика для строительства новой школы, стартовая цена контракта — 2,6 млрд рублей.
- 15:30
-
 Красноярец убил двух косуль в Большемуртинском районе и попал под «уголовку»
6 В Большемуртинском районе Красноярского края полицейские задержали 38-летнего мужчину подозреваемого в незаконной охоте.
Красноярец убил двух косуль в Большемуртинском районе и попал под «уголовку»
6 В Большемуртинском районе Красноярского края полицейские задержали 38-летнего мужчину подозреваемого в незаконной охоте.
- 15:10
-
 В Красноярске на 13 улицах впервые появились фонари
7 В Красноярске смонтировали уличное освещение на 24 участках города. Впервые фонари поставили на 13 улицах.
В Красноярске на 13 улицах впервые появились фонари
7 В Красноярске смонтировали уличное освещение на 24 участках города. Впервые фонари поставили на 13 улицах.
- 15:04
-
 «160 тысяч кубометров за сутки»: КрасЖД вывела на пути спецтехнику для уборки снега
2 На перегонах работают мощные плужные снегоочистители, большие снегоуборочные струги, а также самоходные снегоуборочные поезда.
«160 тысяч кубометров за сутки»: КрасЖД вывела на пути спецтехнику для уборки снега
2 На перегонах работают мощные плужные снегоочистители, большие снегоуборочные струги, а также самоходные снегоуборочные поезда.
- 14:56
-
 Компания «Про-Ток» на Сибирском энергетическом форуме рассказала о перспективных разработках в области возобновляемой энергетики
Компания также презентовала концепт «энергодома» — автономного энергокомплекса для туристических зон и индивидуального строительства.
Компания «Про-Ток» на Сибирском энергетическом форуме рассказала о перспективных разработках в области возобновляемой энергетики
Компания также презентовала концепт «энергодома» — автономного энергокомплекса для туристических зон и индивидуального строительства.
- 14:41
-
 Судебные приставы вернули на работу учительницу из Железногорска
8 Судебные приставы Железногорска восстановили в должности местную учительницу математики, незаконно уволенную из школы.
Судебные приставы вернули на работу учительницу из Железногорска
8 Судебные приставы Железногорска восстановили в должности местную учительницу математики, незаконно уволенную из школы.
- 14:20
-
 Пьяный красноярец попал в ДТП на служебном самосвале и отправился в колонию (видео)
1 42-летнему красноярцу вынесли приговор за нетрезвую езду на служебном самосвале.
Пьяный красноярец попал в ДТП на служебном самосвале и отправился в колонию (видео)
1 42-летнему красноярцу вынесли приговор за нетрезвую езду на служебном самосвале.
- 13:50
-
 Спрос на новостройки в России вырос за месяц более чем на 20 %
14 Спрос подогревают ожидания новых ограничений по семейной ипотеке, которые должны вступить в силу в начале 2026 года.
Спрос на новостройки в России вырос за месяц более чем на 20 %
14 Спрос подогревают ожидания новых ограничений по семейной ипотеке, которые должны вступить в силу в начале 2026 года.
- 13:50
-
 Красноярец получил «условку» за кражу техники из квартиры бабушки своей жены
В Красноярске мужчина вынес всю технику из квартиры бабушки своей жены и получил условный срок.
Красноярец получил «условку» за кражу техники из квартиры бабушки своей жены
В Красноярске мужчина вынес всю технику из квартиры бабушки своей жены и получил условный срок.
- 13:40
-
Ученые из Красноярска рассказали, чем пахнут опасные бактерии
Эксперты Красноярского государственного медицинского университета изучают, как пахнут различные бактерии.
Ученые из Красноярска рассказали, чем пахнут опасные бактерии
Эксперты Красноярского государственного медицинского университета изучают, как пахнут различные бактерии.
- 13:20
-
 «Наша цель — стабильная работа энергосистемы»: «Россети Сибирь» приняли участие в Сибирском энергетическом форуме
1 Одна из ключевых тем — подписание регуляторного соглашения между министерством тарифной политики Красноярского края и «Красноярскэнерго».
«Наша цель — стабильная работа энергосистемы»: «Россети Сибирь» приняли участие в Сибирском энергетическом форуме
1 Одна из ключевых тем — подписание регуляторного соглашения между министерством тарифной политики Красноярского края и «Красноярскэнерго».
- 13:16
-
 Глава правительства края стал кандидатом на пост мэра Красноярска
26 «Единая Россия» официально выдвинула кандидатуру Сергея Верещагина.
Глава правительства края стал кандидатом на пост мэра Красноярска
26 «Единая Россия» официально выдвинула кандидатуру Сергея Верещагина.
- 13:16
-
 Кооперативы Красноярского края получат почти 52 млн рублей на закупку молока и мяса у населения
4 Основное условие — кооперативы должны сохранить объём закупки сельхозпродукции к уровню прошлого года.
Кооперативы Красноярского края получат почти 52 млн рублей на закупку молока и мяса у населения
4 Основное условие — кооперативы должны сохранить объём закупки сельхозпродукции к уровню прошлого года.
- 13:00
-
 Красноярский тренер решил заработать на продаже рецептурных препаратов и оказался в СИЗО
2 Фитнес-тренер из Красноярска организовал канал межрегиональной поставки рецептурных сильнодействующих препаратов для набора мышечной массы.
Красноярский тренер решил заработать на продаже рецептурных препаратов и оказался в СИЗО
2 Фитнес-тренер из Красноярска организовал канал межрегиональной поставки рецептурных сильнодействующих препаратов для набора мышечной массы.
- 12:22
-
 «Задача непростая, но важная»: красноярские пенсионеры благодаря учебному курсу освоили смартфон
7 Мероприятие прошло в рамках социального проекта «Азбука интернета», который провайдер реализует совместно с Социальным фондом России.
«Задача непростая, но важная»: красноярские пенсионеры благодаря учебному курсу освоили смартфон
7 Мероприятие прошло в рамках социального проекта «Азбука интернета», который провайдер реализует совместно с Социальным фондом России.
- 12:21
-
 В Красноярском крае бизнес высоко оценил господдержку при модернизации котельного оборудования
3 В Красноярске первые предприниматели завершили замену устаревшего отопления на современное и экологичное.
В Красноярском крае бизнес высоко оценил господдержку при модернизации котельного оборудования
3 В Красноярске первые предприниматели завершили замену устаревшего отопления на современное и экологичное.
- 11:51
-
 Суд арестовал начальника отдела центра «Э» полиции Красноярского края
25 Начальника отдела Центра противодействия экстремизму полиции Красноярского края подозревают в получении взятки в особо крупном размере.
Суд арестовал начальника отдела центра «Э» полиции Красноярского края
25 Начальника отдела Центра противодействия экстремизму полиции Красноярского края подозревают в получении взятки в особо крупном размере.
- 11:38
-
 В Красноярске открывается каток под открытым небом на стадионе «Локомотив»
2 В Красноярске начал работу сезонный каток под открытым небом на стадионе «Локомотив».
В Красноярске открывается каток под открытым небом на стадионе «Локомотив»
2 В Красноярске начал работу сезонный каток под открытым небом на стадионе «Локомотив».
- 11:19
-
 Красноярские врачи напомнили об опасности самолечения антибиотиками
6 Специалисты Красноярского центра общественного здоровья заявили, что устойчивость к антибиотикам стала одной из серьезнейших угроз для здоровья населения.
Красноярские врачи напомнили об опасности самолечения антибиотиками
6 Специалисты Красноярского центра общественного здоровья заявили, что устойчивость к антибиотикам стала одной из серьезнейших угроз для здоровья населения.
- 10:57
-
 В 2026 году в Красноярском крае вступят в силу новые региональные налоговые законы
1 В Красноярском крае вводят новые региональные налоговые законы. Соответствующие поправки на сессии Законодательного Собрания депутаты приняли в двух чтениях.
В 2026 году в Красноярском крае вступят в силу новые региональные налоговые законы
1 В Красноярском крае вводят новые региональные налоговые законы. Соответствующие поправки на сессии Законодательного Собрания депутаты приняли в двух чтениях.
- 10:54
-
 «Сохраняем спортивные традиции»: в шахтерском Бородине прошел традиционный шахматный фестиваль
Осенние соревнования, как и весенние, были посвящены 80-летию Великой Победы.
«Сохраняем спортивные традиции»: в шахтерском Бородине прошел традиционный шахматный фестиваль
Осенние соревнования, как и весенние, были посвящены 80-летию Великой Победы.
- 10:42
-
 Эксперты проверили фастфуд в Красноярском крае на безопасность
5 Красноярские специалисты выполнили более 500 исследований фастфуда.
Эксперты проверили фастфуд в Красноярском крае на безопасность
5 Красноярские специалисты выполнили более 500 исследований фастфуда.
- 10:40
-
 Подросток из Ачинска угнал ВАЗ отца и вынудил полицейских применить оружие
1 Сотрудники ГАИ Ачинска совместно с коллегами из Большого Улуя задержали 15-летнего бесправника, угнавшего у отца автомобиль.
Подросток из Ачинска угнал ВАЗ отца и вынудил полицейских применить оружие
1 Сотрудники ГАИ Ачинска совместно с коллегами из Большого Улуя задержали 15-летнего бесправника, угнавшего у отца автомобиль.
- 10:16
-
 В Красноярске сгорел автомобиль скорой помощи (видео)
13 В Красноярске автомобиль скорой помощи приехал на вызов на улицу 9 Мая и сгорел.
В Красноярске сгорел автомобиль скорой помощи (видео)
13 В Красноярске автомобиль скорой помощи приехал на вызов на улицу 9 Мая и сгорел.
- 10:00
-
 Пассажиры авиакомпании NordStar могут повысить класс обслуживания со скидкой 50 %
Пассажиры получают возможность разместиться на просторных и удобных креслах с увеличенным пространством для ног, а также приоритетную регистрацию и посадку в самолет.
Пассажиры авиакомпании NordStar могут повысить класс обслуживания со скидкой 50 %
Пассажиры получают возможность разместиться на просторных и удобных креслах с увеличенным пространством для ног, а также приоритетную регистрацию и посадку в самолет.
- 9:00
-
 «Город изнутри»: красноярцев приглашают на бесплатный фестиваль уличного искусства
2 30 ноября в лофт-проекте «Квадрат» (ул. Красной Армии, 10 к4) состоится фестиваль уличной культуры и современного искусства «ИСКРАФЕСТ: город изнутри».
«Город изнутри»: красноярцев приглашают на бесплатный фестиваль уличного искусства
2 30 ноября в лофт-проекте «Квадрат» (ул. Красной Армии, 10 к4) состоится фестиваль уличной культуры и современного искусства «ИСКРАФЕСТ: город изнутри».
- 9:00
-
 Билайн расширил покрытие 4G в более чем 30 малых населенных пунктах Красноярского края
Уверенный сигнал 4G теперь доступен в Мотыгино, где находится единственный в России драмтеатр в поселке численностью менее 5 тысяч человек.
Билайн расширил покрытие 4G в более чем 30 малых населенных пунктах Красноярского края
Уверенный сигнал 4G теперь доступен в Мотыгино, где находится единственный в России драмтеатр в поселке численностью менее 5 тысяч человек.
- 18:40
-
 В Минфине рассказали о параметрах бюджета Красноярского края на 2026-2028 годы
В министерстве финансов Красноярского края рассказали о параметрах бюджета региона на 2026 год и плановый период 2026-2028 годов.
В Минфине рассказали о параметрах бюджета Красноярского края на 2026-2028 годы
В министерстве финансов Красноярского края рассказали о параметрах бюджета региона на 2026 год и плановый период 2026-2028 годов.
- 18:30
-
 Красноярскому бизнесмену Егорову не вернут 157 млн рублей переплаты ущерба по уголовному делу
13 Красноярской стройфирме «Сибиряк» бизнесмена Владимира Егорова не стали возвращать 157 млн рублей, которые та якобы переплатила в бюджет при возмещении ущерба по уголовному делу о строительстве школы.
Красноярскому бизнесмену Егорову не вернут 157 млн рублей переплаты ущерба по уголовному делу
13 Красноярской стройфирме «Сибиряк» бизнесмена Владимира Егорова не стали возвращать 157 млн рублей, которые та якобы переплатила в бюджет при возмещении ущерба по уголовному делу о строительстве школы.
- 18:23
-
 В Красноярске во втором чтении приняли закон о безнадзорных животных
30 В Красноярском крае на сессии Законодательного Собрания во втором чтении приняли закон о безнадзорных животных
В Красноярске во втором чтении приняли закон о безнадзорных животных
30 В Красноярском крае на сессии Законодательного Собрания во втором чтении приняли закон о безнадзорных животных
- 18:10
-
 Ученые разобрали мифы о метеозависимости
4 Специалисты объяснили, что на самом деле стоит за понятием «метеозависимость», которое часто используют для объяснения плохого самочувствия.
Ученые разобрали мифы о метеозависимости
4 Специалисты объяснили, что на самом деле стоит за понятием «метеозависимость», которое часто используют для объяснения плохого самочувствия.
- 18:02
-
 В Красноярске достроили проблемный дом на улице Грунтовой
6 В красноярском микрорайоне Первомайский достроили проблемный 17-этажный дом на Грунтовой.
В Красноярске достроили проблемный дом на улице Грунтовой
6 В красноярском микрорайоне Первомайский достроили проблемный 17-этажный дом на Грунтовой.
- 17:55
-
 В Красноярском крае после ремонта открыли три моста
1 В Красноярском крае завершили капитальный ремонт трех автомобильных мостов.
В Красноярском крае после ремонта открыли три моста
1 В Красноярском крае завершили капитальный ремонт трех автомобильных мостов.
- 17:34
-
 В Красноярске появится 835 новых контейнеров для мусора
4 В Красноярске началась установка 835 новых контейнеров для твёрдых коммунальных отходов (ТКО).
В Красноярске появится 835 новых контейнеров для мусора
4 В Красноярске началась установка 835 новых контейнеров для твёрдых коммунальных отходов (ТКО).
- 17:30
-
 Бензин АИ-92 в Красноярске подорожал на 23 % за год
9 В Красноярске зафиксировали рекордное подорожанием бензина АИ-92.
Бензин АИ-92 в Красноярске подорожал на 23 % за год
9 В Красноярске зафиксировали рекордное подорожанием бензина АИ-92.











